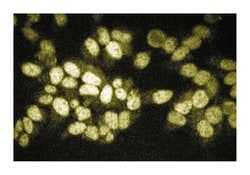
RIP2/RICK Mouse, Unlabeled, Clone: 25, BD 50&mu;g; Unlabeled:Antibodies,

Learn More
RIP2/RICK Mouse, Unlabeled, Clone: 25, BD
Mouse Monoclonal Antibody
Marque: BD Biosciences 612348
Description
Members of the TNFR family (TNFRs, DRs, Fas, lymphotoxin-β-receptor, CD40, CD30, and OX-40) regulate a variety of cellular responses, such as cell activation, proliferation, differentiation, NF-κB activation, and apoptosis. Signaling through TNFR family members involves several families of receptor-associated proteins. RIP and RIP2 (RICK/Cardiak) are ser/thr kinase adaptor molecules that associate with TNFR complexes. Both RIPs contain homologous N-teriminal ser/thr kinase domains, but RIP contains a C-terminal death domain, while RIP2 contains a C-terminal caspase activation and recruitment domain (CARD) similar to those found in IAPs. Both RIP and RIP2 can activate NF-κB and cause cell death. RIP2 is recruited to TNFRs through interactions with TRAF1, TRAF5, and TRAF6, and RIP2 activation of NF-κB requires IKKα, IKKβ, and IKKγ. In addition, RIP2 can be activated through interactions with Ras-activated Raf1, and RIP2 can activate ERK1 and ERK2. Thus, RIP proteins may regulate TNFR signaling through both ser/thr kinase activity and interaction with the apoptotic machinery.
Immunofluorescence, Western Blotting

Spécification
| RIP2/RICK | |
| Monoclonal | |
| 250μg/mL | |
| Aqueous buffered solution containing BSA, glycerol, and ≤0.09% sodium azide. | |
| Human RIP2/RICK aa. 333-532 | |
| 50 μg | |
| Cell Biology | |
| Canine, Human, Rat | |
| IgG1 |
| Western Blot | |
| 25 | |
| Unconjugated | |
| Mouse | |
| Affinity Purified | |
| RUO | |
| Primary | |
| Store undiluted at -20°C. |
Veuillez fournir vos retours sur le contenu du produit en remplissant le formulaire ci-dessous.
For Research Use Only.